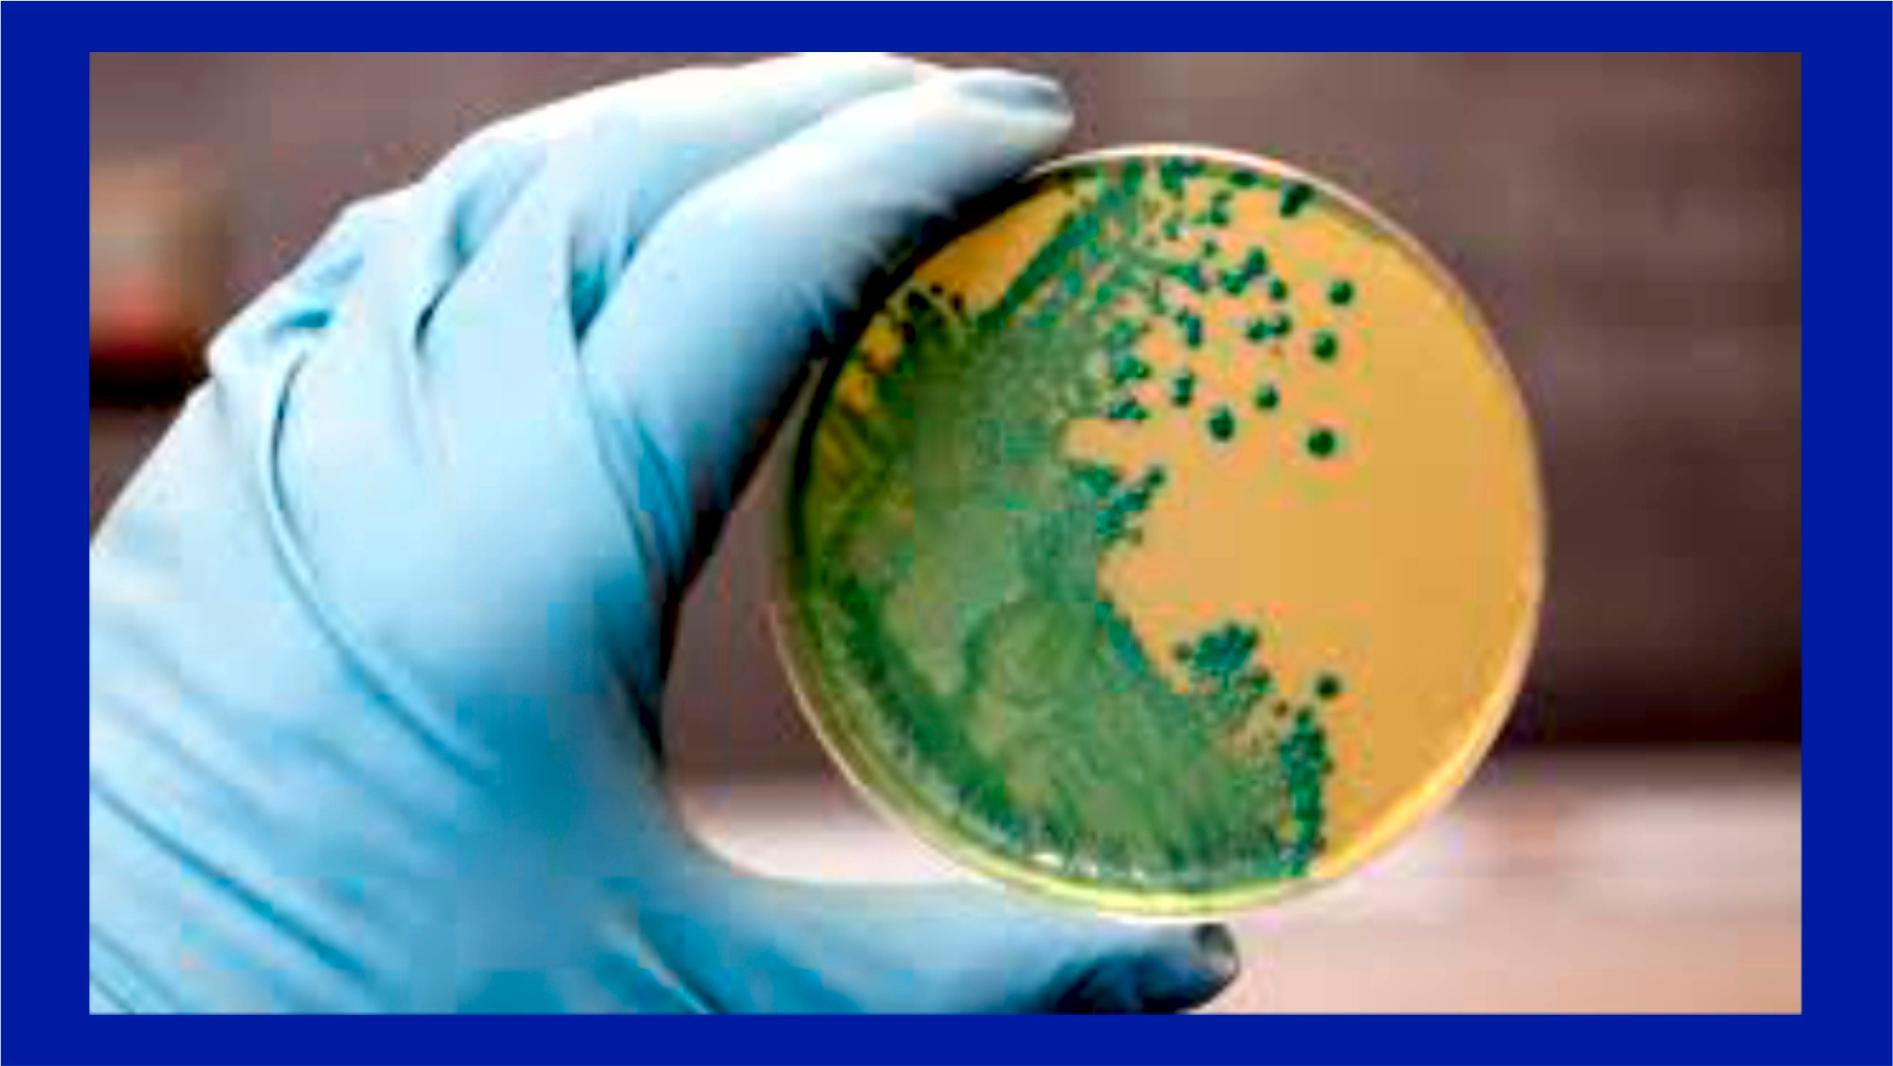
Cover Image

18 august 2025sanatate
Ministerul Sănătății introduce un registru electronic pentru raportarea infecțiilor nosocomiale în spitale
18 august 2025sanatate
Pacienții vor putea raporta online redirecționările abuzive către clinici private
14 august 2025sanatate
Măsuri pentru transparență în spitalele publice
12 august 2025sanatate
Pacienții cronici pot merge direct la medicul specialist, fără bilet de trimitere
12 august 2025sanatate
Vaccinarea gratuită anti-HPV, extinsă până la 26 de ani începând cu 1 octombrie 2025
9 august 2025sanatate
Din 2026, gradual, Cardul de sănătate, înlocuit de cartea electronică de identitate
9 august 2025sanatate
Când Salvatorul devine Agresor. Sau despre cei care îți frâng aripile și apoi te conving că fără ei n-ai fi zburat niciodată
6 august 2025sanatate
Servicii medicale gratuite pentru coasigurați, doar până la 1 septembrie
6 august 2025sanatate
Beneficiarii unor indemnizații sociale rămân asigurați în sistemul de sănătate fără demersuri suplimentare
5 august 2025sanatate
Noi măsuri privind calculul indemnizației pentru concediul medical, în vigoare din 1 august 2025
2 august 2025sanatate
1-7 august, Săptămâna Mondială a Alăptării
2 august 2025sanatate
„La pieptul tău se scrie prima poveste de iubire” De ce este atât de important să-ți alăptezi copilul la sân
29 iulie 2025sanatate
Ministerul Sănătății infirmă transferul serviciilor de Ambulanță către Departamentul pentru Situații de Urgență
26 iulie 2025sanatate
Într-un colț de supermarket, un copil mi-a arătat cum se vede sufletul
24 iulie 2025sanatate
Schimbare majoră pentru medicii de familie, inițiată de Guvernul Bolojan
24 iulie 2025sanatate
Programul medicilor, în atenția autorităților
22 iulie 2025sanatate
Cum devii asigurat în sistemul de sănătate dacă nu ai venituri
21 iulie 2025sanatate
Măsuri pentru protecția animalelor pe timpul caniculei